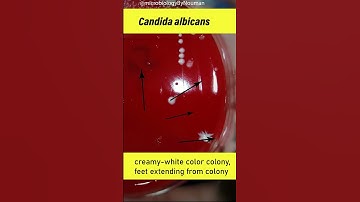
Candida albicans on Blood agar plate #shorts #youtubeshorts

⬇ DOWNLOAD NOW
Kalau muncul iklan pop-up, tutup lalu klik tombol kembali
Download lagu Lab Practical 2 : Morphological structure of Mycology Fungi secara gratis hanya untuk keperluan promosi. Dukung artis favorit kamu dengan membeli musik original di iTunes atau platform resmi lainnya.
 Introduction to Fungi
Introduction to Fungi
Candida albicans on Blood agar plate #shorts #youtubeshorts
Candida albicans on Blood agar plate #shorts #youtubeshorts
 Mycology Lab Practical 2: Transferring of Fungal Cultures
Mycology Lab Practical 2: Transferring of Fungal Cultures
 Mycology Lab Practical 2: Isolation of endophytic fungi
Mycology Lab Practical 2: Isolation of endophytic fungi
 Exploring the fascinating world of fungi with the slide culture technique 🍄🔬| AcentricBiotech Mohali
Exploring the fascinating world of fungi with the slide culture technique 🍄🔬| AcentricBiotech Mohali
 Fungal culture | mycology |SDA fungal culture medium | tjbiologist | microbiology | biology|science
Fungal culture | mycology |SDA fungal culture medium | tjbiologist | microbiology | biology|science
 Microscope Slide Preparation 🔬I Fungal Culture Temporary Slide #slide #microscope #fungal #culture
Microscope Slide Preparation 🔬I Fungal Culture Temporary Slide #slide #microscope #fungal #culture
 Fungal morphology and structure #mycology
Fungal morphology and structure #mycology